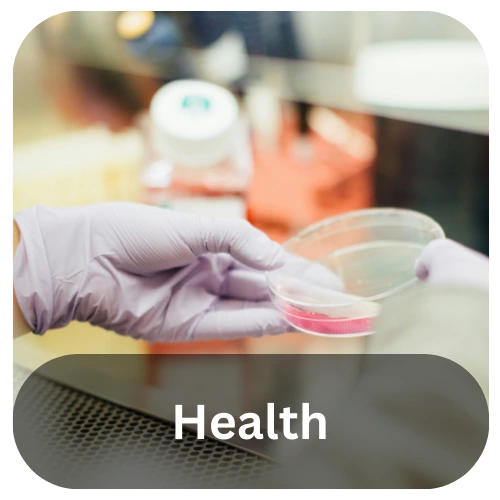

Centre for Applied Bioscience Research (CABR) (Formerly Shannon ABC)

25+
Researchers
110+
Number of Irish Companies We Partnered With
180+
Number of Projects We Worked On
15+
Millions of Euros in Funding Awarded

Welcome to Centre for Applied Bioscience Research (CABR)
Centre for Applied Bioscience Research (CABR) is a commercially focused, state of the art, research centre. It is a collaboration between Technological University of the Shannon: Midlands Midwest and Munster Technological University.
We develop new processes and products from bio-resources and provide the solutions and discoveries to biotech and life science industries.
Centre for Applied Bioscience Research (CABR) identifies innovative ingredients and biological products from natural resources using novel state of the art processes to obtain lead molecules for applications across a range of sectors including but not limited too food & drink, healthcare, cosmetics, agriculture, marine, nutraceutical, bio/pharma.
The Centre has a strong history of collaboration with industry in the area of bioactive compounds, as well as the broader Irish biotechnology sector, and was established through funding co-financed by the European Regional Development Fund and Enterprise Ireland under the Applied Research Enhancement (ARE) Program.
Facilities & Resources
Centre for Applied Bioscience Research (CABR) have 1,000 square feet of laboratory space at TUS and MTU. Within this resource there is a range of equipment and facilities that are committed to industry collaboration and use-inspired research. Please see equipment link for more information.
Funding
Centre for Applied Bioscience Research (CABR) have over a decade of experience of helping Irish enterprises with their R&D needs.
Our experienced staff have significant experience in writing and securing funding for all types of research, and are well-placed to support Irish industry in a range of grant applications, including Innovation Vouchers, Innovation Partnerships and European funding applications.
To find out about some of the most commonly used funding options that may be available for your organisation, please see funding support for more details.
Research Expertise
In parallel to our industry focussed research, Centre for Applied Bioscience Research (CABR) also engages in use-inspired research in a range of areas including fungal biotechnology, bioeconomy, marine biotechnology, plant biotechnology and cell culture research. Please see research expertise for more detail.